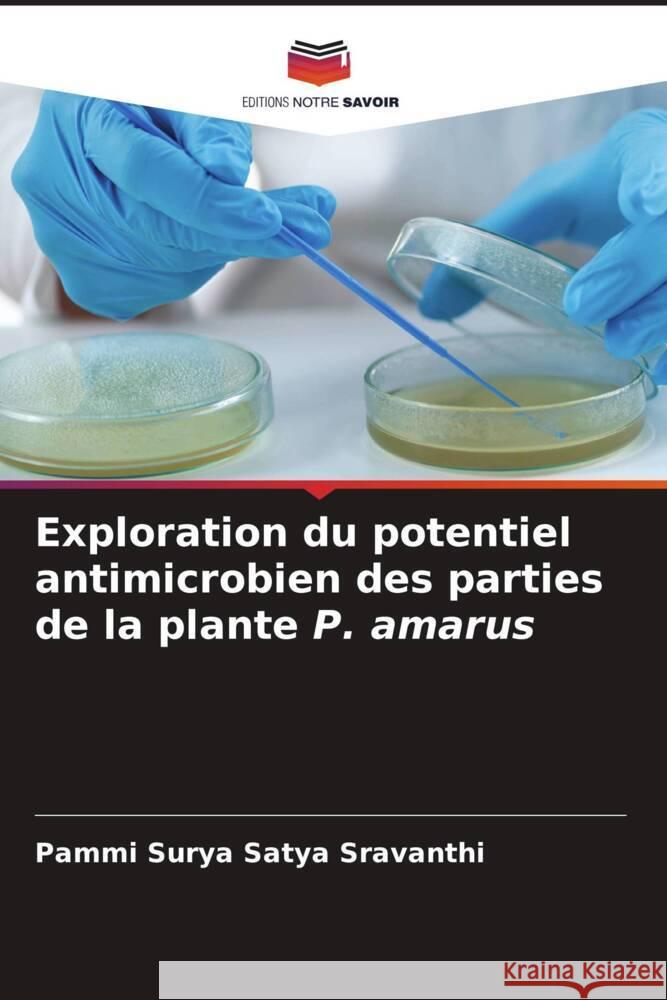
Exploration du potentiel antimicrobien des parties de la plante P. amarus Surya Satya Sravanthi, Pammi 9786137363041 Editions Notre Savoir - książka

Exploration du potentiel antimicrobien des parties de la plante P. amarus » książka
Exploration du potentiel antimicrobien des parties de la plante P. amarus
ISBN-13: 9786137363041 / Francuski / Miękka / 2025 / 100 str.
Les métabolites secondaires des plantes se sont révélés être une source inestimable de produits pharmaceutiques grâce à leurs diverses propriétés biologiques, notamment leurs effets antiviraux, antibactériens, antioxydants et anticancéreux. Les métabolites secondaires sont des sources uniques pour les produits pharmaceutiques, les additifs alimentaires, les arômes et d'autres applications industrielles. L'importance commerciale de ces métabolites secondaires a suscité un grand intérêt pour l'exploration de leurs possibilités ces dernières années. Les terpénoïdes, les alcaloïdes, les composés phénoliques et les flavonoïdes sont quelques-uns des composés bioactifs qui contribuent à la valeur médicinale d'une plante. L'herbe Phyllanthus amarus est largement utilisée dans les pays tropicaux, notamment en Inde. Elle a des usages traditionnels importants. Compte tenu du vaste potentiel de cette plante en tant que source de médicaments antimicrobiens, la présente étude s'efforce de donner un aperçu de l'analyse phytochimique et des propriétés antimicrobiennes de Phyllanthus amarus, qui peuvent être utiles pour des études plus approfondies sur cette plante.